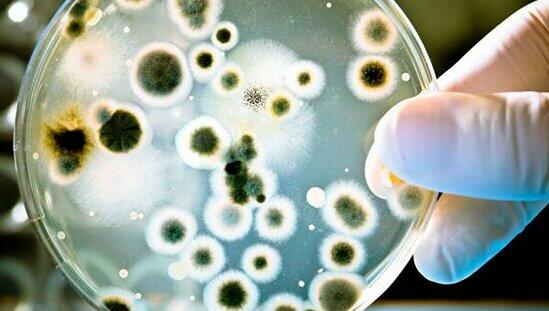

Günlərdir isti havalar vətəndaşların yuxu keyfiyyətinə mənfi təsir göstərsə də, mütəxəssislər yuxu keyfiyyəti ilə yanaşı gigiyenik mühitdə yatmağın vacibliyini diqqətə çatdırıblar.
Publika.az xəbər verir ki, bu səbəbdən yastıq gigiyenasının çox vacib olduğunu qeyd edən mütəxəssislər, xüsusilə də tərin çox olduğu yay aylarında yastıq üzlüklərinin tez-tez dəyişdirilməsini tövsiyə ediblər.
Yastıq üzləri tualetdən daha çox bakteriyalı ola bilər. Mütəxəssislər evlərdə olan gizli təhlükələrdən də danışıblar:
“Evi istədiyiniz qədər təmizləsəniz də, bəzi əşyaları dəyişdirməlisiniz. Bu təhlükələrdən birincisi sizinlə birlikdə yaşamağa davam edən yatağınızdadır. Yastıq üzündə ölü hüceyrələr və yağlar bakteriyaların çoxalması üçün ən uyğun zəmin yaradır. Bu səbəblə xüsusilə yay aylarında yastıq gigiyenasına maksimum diqqət yetirilməlidir”.
Aysel Şahmar